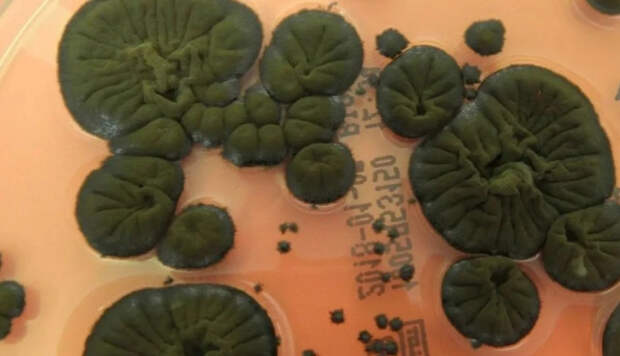

В Чернобыльской зоне нашли уникальный черный гриб Cladosporium sphaerospermum, который не только выживает в условиях экстремальной радиации, но и может использовать ее для своего роста.
Питающийся радиацией черный гриб нашли на стенах разрушенного энергоблока в Чернобыле, пишет ScienceAlert.
Ученых привлекло необычное поведение гриба.
По их мнению, темный пигмент меланин в клетках гриба способен поглощать энергию ионизирующего излучения и преобразовывать её для жизнедеятельности.
Радиосинтез пока не доказали, но эксперименты дали неожиданный результат. Выяснилось, что при радиации данный гриб растет, а не погибает. Этот феномен противоречит привычной биологической реакции на облучение.
Отмечается, что первые колонии темных грибов нашли в разрушенном реакторе еще в конце 1990 годов.
Исследования показали, что они являются устойчивыми к высоким уровням радиации. Ученых удивили способности этих грибов, так как некоторые организмы лишь увеличивают содержание меланина, но не растут.
Свежие комментарии